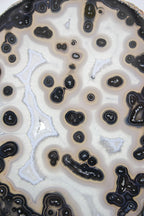
Uruguayan agate slice

About Rockology
Rockology is the premier vendor of gem show quality specimens available online - for both wholesale and retail. Our amethyst, agate, and other rare minerals are all hand selected and truly one of a kind! Feel free to reach out with any custom material or purchasing requests. We love working closely with our valued clients to ensure a top purchasing experience.